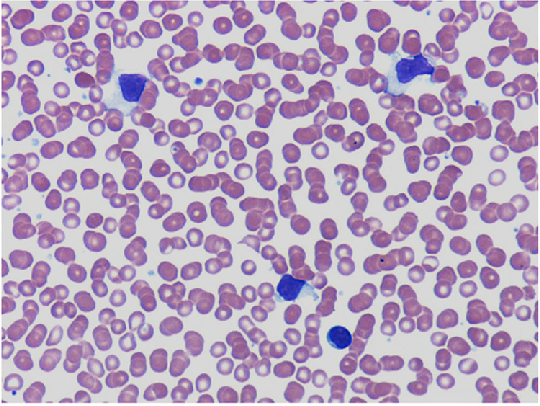

바이러스 감염 (2)
거대세포바이러스 (Cytomegalovirus, CMV)
감염 형태
선천성 감염: 태아가 자궁 내에서 감염. 신생아 감염의 가장 흔한 원인 (0.2-2.2%).
주산기 감염: 분만 중 또는 모유 수유를 통해 감염 (6-12% ~ 40%).
후천성 감염: 출생 후 감염. 면역 정상인에서는 대부분 무증상
임상양상
선천성 감염: 소두증, 간비대, 혈소판 감소증, 뇌내 석회화, 감각신경성 난청 등 심각한 후유증 유발 가능.
주산기/후천성 감염: 면역 정상 소아는 대부분 무증상이나 일부에서 감염단핵구증 유사 증상(발열, 간염)을 보임.
면역저하자 감염: 폐렴, 망막염, 위장관염 등 심각한 기회감염을 일으킴
진단 및 검사
혈청학적 검사: 혈액 또는 소변에서 CMV IgM 항체 검출 시 급성 감염 시사.
바이러스 검출: 소변, 타액, 혈액 PCR
치료
면역약화자: 치명적인 CMV 감염이 있는 경우 IV ganciclovir + CMV-specivic IVIG 투여
선천 감염: 증상이 있는 선천감염의 경우 valganciclovir / ganciclovir 투여
(증상이 없는 경우 치료하지 않음)
Epstein-Barr 바이러스 (EBV)
주요 질환
감염성 단핵구증 (Infectious Mononucleosis)
버킷 림프종, 비인두암 등과 관련
임상 양상
Triad: 발열 (90%), 인후통 및 편도 비대 (kissing tonsils, 회백색 삼출물 동반) , 전신 림프절 종대 (주로 경부 침범)
심한 피로감, 간/비장비대, 간수치 상승, 안검 부종, 구개 점상출혈
Ampicillin, Amoxicillin 투여 시 80% 이상에서 전신성 반점구진성 발진 발생
진단 및 검사
말초혈액 도말검사: 비정형 림프구(Atypical lymphocyte)가 10% 이상 증가
이종친화항체 검사: 간편한 선별 검사이나 4세이하 소아에서는 양성률 50%
EBV 특이 항체 검사: 가장 정확한 진단법. 감염 시기에 따라 항체 반응이 다름
합병증: 비장 파열(0.1-0.5%), 인두부/기도폐쇄, 뇌수막염, 용혈빈혈/ 혈소판감소증/중성구감소증, 심근염, 사이질 폐렴, 췌장염/귀밑샘염. 혈구탐식성 림프조직구증
치료 및 합병증
치료: 대부분 대증요법. 충분한 휴식과 수분 공급이 중요함
스테로이드 적응증 : 기도폐쇄, 혈소판 감소증, 용혈성 빈혈, 경련 등
인간 헤르페스 바이러스 6형 및 7형 (HHV-6, HHV-7)
주요 질환: 영아 돌발진 (Exanthem Subitum, Roseola Infantum), 주로 HHV-6에 의해 발생
임상양상
3-5일간의 고열(39-40°C) 후, 열이 내리면서 몸통에서부터 얼굴, 팔다리로 퍼지는 장미빛 반점 또는 반점구진성 발진이 나타남
진단: 병력 및 임상양상으로 진단
치료: 해열제 및 대증요법
합병증: 열성 경련이 가장 흔한 합병증
호흡기 세포융합 바이러스 (Respiratory Syncytial Virus, RSV)
역학: 매년 겨울철에 유행하며, 2세까지 거의 모든 소아가 감염됨
임상양상
초기 증상: 콧물, 기침 등 상기도 감염 증상으로 시작
진행 시: 쌕쌕거림(wheezing), 호흡 곤란, 빈호흡, 흉부 함몰 등 하기도 감염 증상 발현.
고위험군: 미숙아, 선천성 심장질환, 만성 폐질환, 면역저하 소아에서 중증으로 진행될 위험이 높음
천식, chlamydia 폐렴 등과의 감별 필요
진단: 임상적 진단, 비인두 흡인물에서 신속 항원 검사/RT-PCR
치료
보존적치료 (수액공급, 가습 산소투여)가 원칙
ribavirin: 선천 심질환, BPD 환아에서 고려 가능하나 효과 불분명
예방: nirsevimab, palivizumab
** nirsevimab이 최근 모든 영유아를 대상으로 도입되었음. 소아예방접종 단원 참고
기타 주요 호흡기 바이러스
파라인플루엔자 바이러스 (Parainfluenza Virus)
영유아 급성 폐쇄성 후두염(크룹, Croup)의 가장 흔한 원인
'개 짖는 듯한' 기침(barking cough), 쉰 목소리, 흡기성 천명(stridor)이 특징
치료: 흡입용 스테로이드(Budesonide) 또는 전신 스테로이드(IM/PO), 중증 시 에피네프린 분무 요법
아데노바이러스 (Adenovirus)
다양한 혈청형이 존재하여 여러 임상 증후군을 유발
인두결막열(Pharyngoconjunctival fever), 급성 출혈성 방광염, 폐렴, 위장관염 등
치료: 대부분 대증요법. 면역저하자에서 중증 감염 시 Cidofovir 고려
합병증
아데노바이러스 폐렴: 기계 호흡이 필요한 호흡부전으로 진행 (특히 면역약화환자 위험)
심한 폐렴 후에 만성 폐질환, bronchiolitis obliterans 등의 후유증 흔함
영유아에게 매우 심각한 괴사성 폐렴(Necrotizing pneumonia) 유발 가능
유행성 각막 결막염에 의한 시력 상실 위험
이식 환자: 파종성 감염 또는 폐렴 발생 시 치사율 60~80% 육박
[1] 홍창의 12e, pg. 502-516
연습문제 17문제
0/17 완료
0개의 글
** 제목만 보더라도 어떤 내용인지 알 수 있도록 완성된 문장으로 작성해주세요.
예시) 초음파 (X) → 초음파 사진에서 PDA 소견을 어떻게 알 수 있나요? (O)